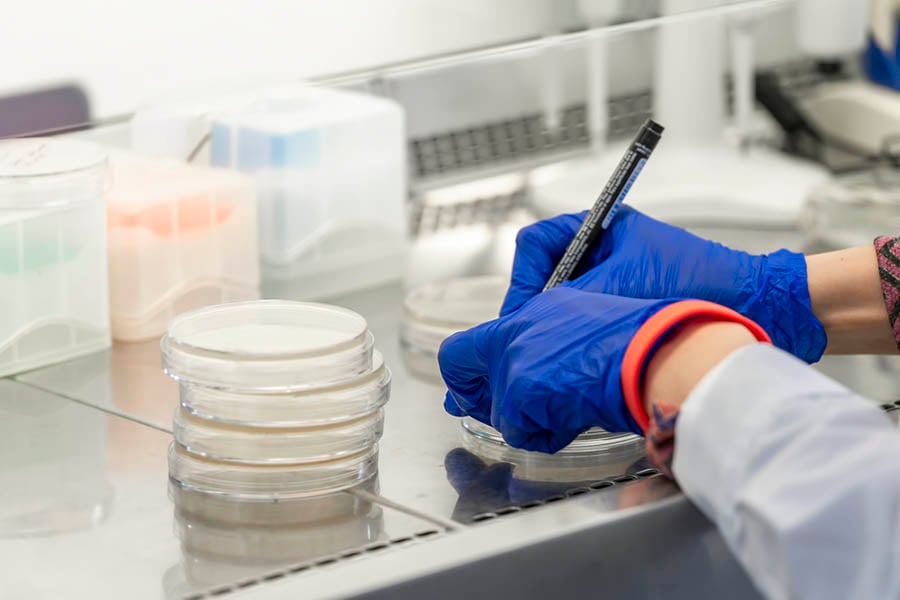
лечение на гонорея

Методи за лечение на гонорея

Гонореята, наричана още трипер, е инфекция, предавана по полов път (ППИ), която представлява значителен риск за здравето, ако не се лекува. Докато в миналото са се прилагали странни и в повечето случаи неуспешни лечебни практики, с напредъка на медицината и науката съвременното лечение на гонорея в повечето случаи е успешно.
Защо гонореята е опасно състояние?
Гонореята може да доведе до сериозни здравословни усложнения, ако не се лекува навреме. Инфекцията се разпространява в други части на тялото и дори в кръвообращението, причинявайки сериозни последици.
Усложненията, които могат да настъпят при жените, са следните:
- Тазова възпалителна болест (PID от Pelvic Inflammatory Disease): нелекуваната гонорея може да се разпространи в матката, фалопиевите тръби и яйчниците, причинявайки PID. Това състояние води до хронична болка в таза, извънматочна бременност (при която оплодената яйцеклетка се имплантира извън матката) или безплодие поради увреждане на репродуктивните органи.
Усложненията, които могат да настъпят при мъжете, са следните:
- Епидидимит: това е възпаление на епидидима (тръбичка, която носи сперматозоиди от тестисите), което води до болка, подуване и в тежки случаи безплодие, ако инфекцията причини белези.
- Простатит: инфекцията може да се разпространи в простатната жлеза, причинявайки болка по време на уриниране, еякулация и хронична болка в таза.
- Уретрит: това е възпаление на уретрата, което може да предизвика чувство на сърбеж, дискомфорт, изгаряне или болка при уриниране.
Разпространена гонококова инфекция
Ако бактериите на гонорея навлязат в кръвния поток, това може да причини разпространена гонококова инфекция, което е тежко и животозастрашаващо състояние.
Симптомите включват:
- Артрит: болезнено подуване на ставите.
- Дерматит: кожни лезии, които могат да бъдат пустуларни или хеморагични.
- Ендокардит: инфекция на сърдечните клапи, която може да бъде фатална.
- Менингит: възпаление на мембраните около главния и гръбначния мозък, което също може да бъде фатално.
Усложнения по време на бременност
При бременни жени нелекуваната гонорея може да доведе до:
- Спонтанен аборт или преждевременно раждане. Съществува повишен риск от спонтанен аборт или преждевременно раждане.
- Неонатални инфекции. Бебето може да се зарази с инфекцията по време на раждането, което води до сериозни състояния като неонатален конюнктивит (който може да причини слепота) или системни инфекции като сепсис.
Повишен риск от предаване на ХИВ
Хората с гонорея са по-склонни да предават и да се заразят с ХИВ поради компрометираната цялост на лигавичните бариери.
Как можем да се предпазим?

Превенцията е ключова за намаляване на разпространението на гонорея. Ограничаването на сексуалните партньори и редовното изследване за ППИ също са важни превантивни мерки. Въздържането от рисково сексуално поведение или наличието на моногамна връзка с неинфектиран партньор може да намали риска от предаване на гонорея в глобален план.
Какви са методите на лечение на гонорея?
Основното лечение на гонорея е с антибиотици. Въпреки това поради нарастващата антибиотична резистентност, изборът на антибиотици може да варира. Често използваните антибиотици за лечение на гонорея в момента включват цефтриаксон, цефиксим и азитромицин. В някои случаи може да е необходима двойна терапия с два различни антибиотика, за да се осигури ефективност.
Пеницилинът някога е бил основно лечение на гонорея, но с течение на времето обаче много щамове на Neisseria gonorrhoeae са развили резистентност към пеницилин и други антибиотици, което ги прави неефективни за лечение на инфекцията. Появата на резистентни към пеницилин щамове на гонорея предизвика преминаване към цефалоспорините.
Цефалоспорините са клас антибиотици, които са структурно и функционално подобни на пеницилина. Те са полусинтетични производни на антибактериалното вещество на гъбичката Acremonium и подобно на пеницилина действат чрез инхибиране (потискане) на синтеза на бактериалната клетъчна стена, което води до смърт на бактериална клетка.
Важно е предприетото лечение на гонорея да се извършва под наблюдението на медицински специалист, за да се гарантира ефективността на терапията и да се предотвратят усложнения и резистентност.
Възможно ли е да се появят усложнения?
Възможните усложнения при гонорея, които изброихме в началото на статията, могат да възникнат, ако инфекцията не се лекува. Друг проблем може да бъде появата на устойчиви на антибиотици щамове на Neisseria gonorrhoeae, което да направи направи лечението на заболяването все по-предизвикателно.
Възстановяване и профилактика
След завършване на предписания курс на антибиотици се препоръчва хората с гонорея да се подложат на последващо изследване, за да се гарантира, че инфекцията е била успешно излекувана. По време на лечението и до потвърждение за излекуване е препоръчително да се избягват сексуални контакти.
Също така е важно да уведомите скорошни сексуални партньори, които също може да се нуждаят от изследване и лечение. За да се предотврати повторно заразяване при полов акт, хората трябва да продължат да практикуват безопасен секс и да се подлагат на редовни прегледи за ППИ.
Гонорея – лечение в миналото
Смята се, че произходът на гонореята датира от векове, ако не и от хилядолетия. Още папирусът на Еберс, египетски медицински документ от около 1550 г. пр. н. е., споменава за полово преносими заболявания, чиито симптоми наподобяват тази инфекция.
Още Хипократ описва състояние, наподобяващо гонорея около 400 г. пр.н.е., докато Гален също отбелязва подобни симптоми. Самият термин, произлизащ от гръцките думи „gonos“ (семе) и „rhea“ (поток), е измислен от Гален.
През цялата история са използвани различни лечения в опит за борба с гонореята. Древните лекарства включвали билкови смеси, лапи и дори талисмани за предпазване от болестта.
През Средновековието гонореята често е била обвита в суеверия и погрешни схващания. Обикновено се е свързвала с морални недостатъци и божествено наказание. Най-често срещаното лечение на гонорея е включвало кръвопускане и други странни днес практики. В ранния модерен период съединенията на основата на живак са били често използвани, въпреки техните токсични странични ефекти.
Гонореята често се е бъркала със сифилиса поради някои припокриващи се симптоми. Това объркване е довело до използването на леченията, предназначени за сифилис, включително прословутата фумигация с живачни пари. Излагането на пациента на пари от живачни съединения е причинявало бъбречни, белодробни, кожни, неврологични и други тежки увреждания.
Терминът „clap„, с който се нарича гонореята, произлиза от френската дума „clapier„, което означава публичен дом и се използвал за обозначаване на разпространението на инфекцията в тези среди.
Също така се смята, че се отнася и до пляскането с ръце, чрез което засегнатите от инфекцията мъже са се опитвали да изкарат специфичния секрет от пениса.
Гонореята се споменава в различни произведения на изкуството и литературата през цялата история, често символизирайки моралния разпад на обществото. Тя се открива в изкуството на Франсиско Гоя и пиесите на Шекспир.
В търсенето на лек

По време на Ренесанса лекарите започват да разграничават различните заболявания и да разработват по-систематични подходи за диагностика и лечение. Въпреки това погрешните схващания за гонореята продължават и ефективните лечения остават неуловими.
Деветнадесети век обаче носи значителен напредък за правилното разбиране и лечение на гонореята. През 1879 г. бактерията Neisseria gonorrhoeae е идентифицирана от немския лекар Алберт Найсер, отбелязвайки ключов момент в историята на болестта. Това откритие поставя основите за разработването на целеви лечения и диагностични методи.
Въвеждането на антисептици като карболовата киселина (фенол) от Джоузеф Листър през 19 век в медицинската практика революционизира лечението на инфекциите.
Сребърният нитрат е бил използван като ранен антисептик при лечение на гонорея, но едва с откритието на пеницилина през двадесети век ефективните възможности за лечение стават широко достъпни.
С откриването на пеницилина от Александър Флеминг през 1928 г. и последвалото му масово производство през 40-те години на миналия век започва нова ера в лечението на бактериалните инфекции.
По-късно разработването на Prontosil, първият синтетичен антибиотик, също показва ефект срещу бактериални инфекции, включително и гонореята. Prontosil забавя растежа на бактериите, действайки като инхибитор на бактериалната репликация.
Пеницилинът обаче се оказва много по-ефективен и има по-малко странични ефекти, което го прави предпочитаното за гонорея лечение и други бактериални инфекции. Бързото му действие и способността му да изчиства напълно инфекциите измества употребата на сулфонамидите.
С течение на времето Neisseria gonorrhoeae развива резистентност към пеницилина и други антибиотици. Тази резистентност се появява в резултат на генетични мутации и прекомерната употреба и злоупотреба с антибиотици, което представлява значително предизвикателство за общественото здраве.
Заключение
Гонореята остава проблем за общественото здраве, особено поради нарастването на резистентните към антибиотици щамове. Въпреки това с навременна диагноза, подходящо лечение и превантивни мерки, разпространението може да бъде сведено до минимум и нейното въздействие върху индивидуалното и общественото здраве да бъде смекчено.
Често задавани въпроси
Какво представлява гонореята?
Гонореята е полово предавана инфекция, предизвикана от бактерията Neisseria gonorrhoeae, която засяга гениталната област, гърлото или очите.
Какви са методите за лечение?
Лечението на гонорея обикновено включва антибиотици, като например цефтриаксон или азитромицин. Поради нарастващата резистентност към антибиотиците лекарят може да предложи комбинация от различни антибиотици или алтернативни лечебни стратегии.
Защо гонореята е опасно състояние?
Гонореята е опасна поради възможните сериозни здравни усложнения, лесното разпространение чрез полов контакт и нарастващата резистентност към антибиотици, което затруднява лечението.
Източници
Блог
Рецепти
Популярни продукти
Свързани публикации
Наличието на хламидия при мъжете може да може да доведе до уретрит, епидидимит, безплодие, реактивен артрит и други усложнения.
В статията разглеждаме съвременното лечение на сифилис и възможните усложнения.
Сифилисът е заболяване, което се предава по полов път, изразено с характерна симптоматика.







